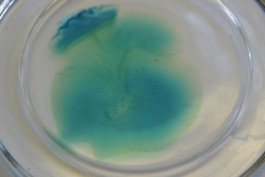

Pheno
2012
In a time with fast technological progress in the natural sciences it gets more and more important to look back on how phenomena originate. Functional principles from nature can help to optimize already developed systems or to produce innovative technologies. Next to fields of applications in technical product areas there are endless possibilities in interdisciplinary work. Concerning new technologies, it is not easy to draw a line between science and design which results in increasing collaboration between engineers, academics and designers.
In my work I try to examine these borders by the interaction between chemical products and the field of design. It is about „changing textures“, surfaces which reassemble themselves in a periodical way. Through their diverse appearance these „living material" can achieve more functions and become more versatile because they adopt to outer factors.